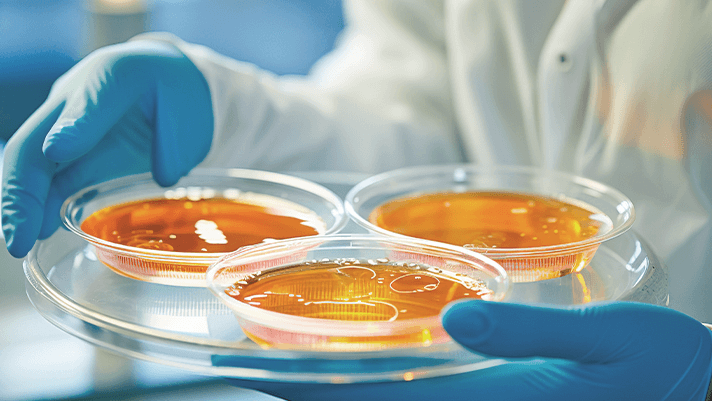
como-la-fermentacion-de-precision-crea-compuestos-medicinales

Introducción
La fermentación de precisión se ha consolidado como una tecnología revolucionaria en la producción de compuestos medicinales, ofreciendo una alternativa eficiente y sostenible a los métodos tradicionales. Mediante el uso de microorganismos modificados genéticamente, este proceso permite sintetizar moléculas terapéuticas con alta pureza y especificidad. es un tema clave para entender avances en tratamientos para enfermedades crónicas, vacunas y principios activos farmacéuticos. Además, su escalabilidad y menor impacto ambiental la posicionan como una solución prometedora para el futuro de la medicina. Este artículo explora sus fundamentos, aplicaciones y beneficios en el ámbito de la salud.
Cómo la fermentación de precisión revoluciona la producción de compuestos medicinales
1. ¿Qué es la fermentación de precisión y cómo funciona?
La fermentación de precisión es un proceso biotecnológico que utiliza microorganismos modificados genéticamente, como bacterias o levaduras, para producir compuestos específicos bajo condiciones controladas. En el contexto de compuestos medicinales, estos microorganismos son programados para sintetizar moléculas terapéuticas, como insulina o anticuerpos, mediante rutas metabólicas optimizadas. Este método permite una producción más eficiente y escalable que los enfoques tradicionales.
2. Ventajas de la fermentación de precisión en la medicina
Entre las principales ventajas de utilizar la fermentación de precisión para crear compuestos medicinales se encuentran: mayor pureza del producto, reducción de costos a largo plazo, menor dependencia de fuentes animales o vegetales, y la capacidad de producir moléculas complejas difíciles de sintetizar químicamente. Además, este método reduce el impacto ambiental en comparación con los procesos convencionales.
3. Ejemplos de compuestos medicinales producidos por fermentación de precisión
La fermentación de precisión ya se utiliza para fabricar diversos compuestos medicinales, como: – Insulina humana para tratar diabetes – Hormonas de crecimiento – Vacunas recombinantes – Enzimas terapéuticas – Anticuerpos monoclonales
4. El proceso paso a paso de la fermentación de precisión
El proceso de crear compuestos medicinales mediante fermentación de precisión sigue estas etapas: 1. Diseño genético del microorganismo 2. Cultivo en biorreactores controlados 3. Monitoreo y optimización de parámetros 4. Extracción y purificación del compuesto 5. Control de calidad y formulación final
5. Futuro de la fermentación de precisión en la industria farmacéutica
La fermentación de precisión está transformando la producción de compuestos medicinales, con perspectivas de expandirse a áreas como medicina personalizada y tratamientos innovadores para enfermedades raras. Su capacidad para producir compuestos más puros y eficaces a menor costo está impulsando su adopción en la industria farmacéutica.
| Componente | Función | Ejemplo en Medicina |
|---|---|---|
| Microorganismos modificados | Fábricas biológicas | Levaduras productoras de insulina |
| Biorreactores | Ambiente controlado | Producción de vacunas |
| Medios de cultivo | Nutrición microbiana | Síntesis de anticuerpos |
| Sistemas de purificación | Aislamiento del compuesto | Obtención de enzimas terapéuticas |
Preguntas Frecuentes
¿Qué es la fermentación de precisión y cómo funciona en la producción de compuestos medicinales?
La fermentación de precisión es un proceso biotecnológico que utiliza microorganismos modificados genéticamente, como bacterias o levaduras, para producir compuestos medicinales específicos. Estos microorganismos se cultivan en biorreactores bajo condiciones controladas, donde se alimentan con nutrientes y realizan reacciones metabólicas que generan los principios activos deseados, como insulina o anticuerpos monoclonales.
¿Cuáles son las ventajas de usar fermentación de precisión en lugar de métodos tradicionales?
La principal ventaja es su mayor precisión y eficiencia, ya que permite producir moléculas complejas sin depender de fuentes animales o plantas, reduciendo costos y tiempo. Además, es más escalable, evita contaminantes y ofrece un menor impacto ambiental al reducir el uso de recursos naturales como tierras de cultivo.
¿Qué tipos de compuestos medicinales pueden obtenerse mediante fermentación de precisión?
Este método puede generar una amplia variedad de compuestos, incluyendo proteínas terapéuticas, enzimas, vacunas y principios activos para fármacos, como la insulina humana, hormonas de crecimiento o incluso compuestos anticancerígenos. Su flexibilidad permite adaptar los microorganismos para sintetizar moléculas complejas difíciles de obtener químicamente.
¿Cómo se garantiza la seguridad y pureza de los compuestos producidos por fermentación de precisión?
Los productos pasan por rigurosos procesos de purificación, como cromatografía o filtración, y se someten a controles de calidad para verificar su pureza y eficacia. Las regulaciones sanitarias exigen pruebas de ausencia de contaminantes y validación de lotes, asegurando que cumplan con los estándares farmacéuticos antes de su uso en pacientes.



















